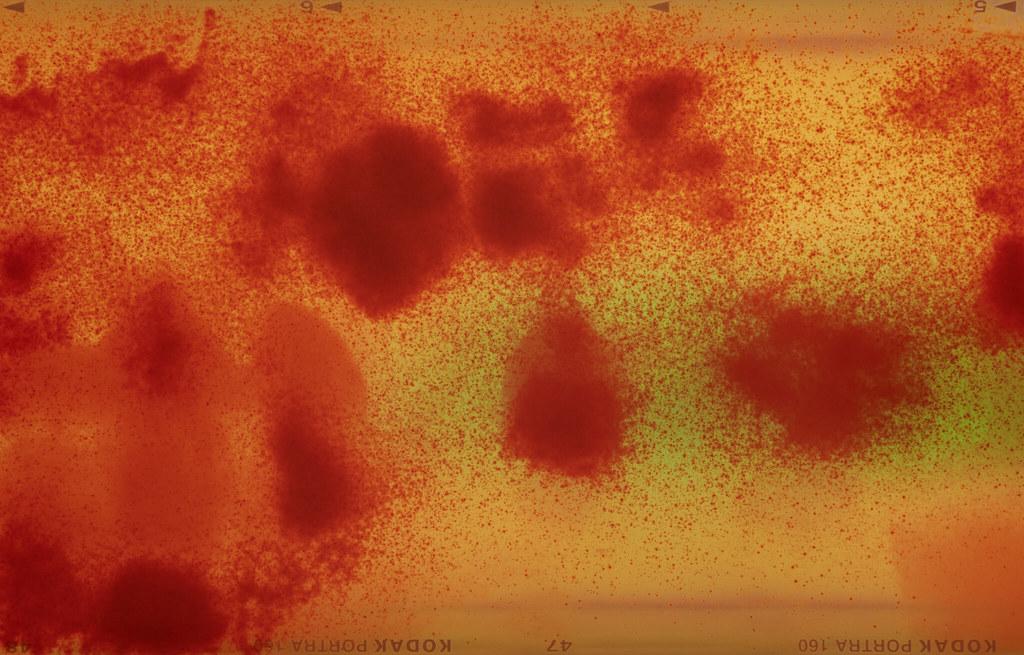

Dunkelkammerdialoge

Verbindung zu esel.at
organized by Anna Watzinger (Mz*Baltazar’s Laboratory)
Vernissage: Friday 24.10.2025, 7pm
Introduction: Ruth Horak
Exhibition: 25. – 31. Oktober 2025
Opening hours: Thursday – Sunday, 3pm – 7pm
Artist Talk: Sunday 26.10.2025, 4pm
Moderation: Margit Neuhold
Finissage: Friday 31.10.2025, 7pm
Corinne Futterlieb (CH) and Claudia Rohrauer (AT) share a long-standing professional and artistic interest in analogue photography and the photo lab. Following initial joint projects at the Photoforum Pasquart in Biel (CH), where the two shared a space in the 2023 exhibition FOTOTECHNIKA III, and the 2024 symposium Photography after immateriality in Bern, the exhibition Darkroom Dialogues continues the artists’ exchange of ideas.
Futterlieb and Rohrauer address the question of the nature of analogue photography by examining the chemical and physical foundations of analogue processes and their materiality. They focus on working in the darkroom and the practical knowledge that comes from personal involvement in the processes and direct observation of them through craftsmanship. The fleeting moments of insight that arise in this way are made tangible through text and images. The artists appear as performative laboratory workers: with a mixture of seriousness and lightness, they move critically and with curiosity in the grey area between the desire to control material and process and the letting go of this control towards a “letting happen” on the material level, towards a possible end of process control itself. The two are interested in visualising and depicting this process-oriented way of working, while at the same time raising questions about the image motif, what is actually depicted, and the interpretative viewing of forms reminiscent of scientific imagery.
In the exhibition, the two artists’ individual approaches to their work are juxtaposed with works created collaboratively during a joint darkroom retreat in the summer of 2025. The elusive ‘experience in the darkness of the laboratory’ takes on an artistic form and becomes accessible to the outside world. The focus is on the search for the ‘it’ of photography, which emerges in the dialogue between material, chemistry and processing and sabotages the codification of photography as a medium of representation and reproducibility. Reactions in film material and chemistry are provoked rather than produced, and these ultimately become seemingly image-less images. The process is turned into the motif.